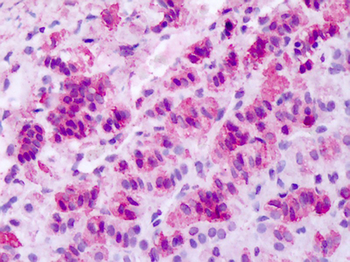
MCHR1 Antibody

You have no items in your shopping cart.
Search results for: 'GPR24'
- MCHR1 Antibody (C-term) [orb1938790]
FC, IHC-P, WB
Human
Mouse, Rat
Rabbit
Polyclonal
Unconjugated
50 μl, 100 μl - Featured
 Featured
Featured
Human
0.32-20 ng/mL
0.111 ng/mL
96 T, 48 T - Featured

FC, IHC, WB
Human
Rabbit
Polyclonal
Unconjugated
200 μl, 100 μl, 50 μl, 30 μlWB
Human, Mouse
Human
Rabbit
Polyclonal
Unconjugated
100 μl- Featured
 Featured
Featured
ELISA, IHC, WB
Human
Rabbit
Polyclonal
Unconjugated
50 μg, 100 μg - Featured
 Featured
Featured
ELISA, IHC, WB
Human, Mouse, Rat
Rabbit
Polyclonal
Unconjugated
50 μg, 100 μg